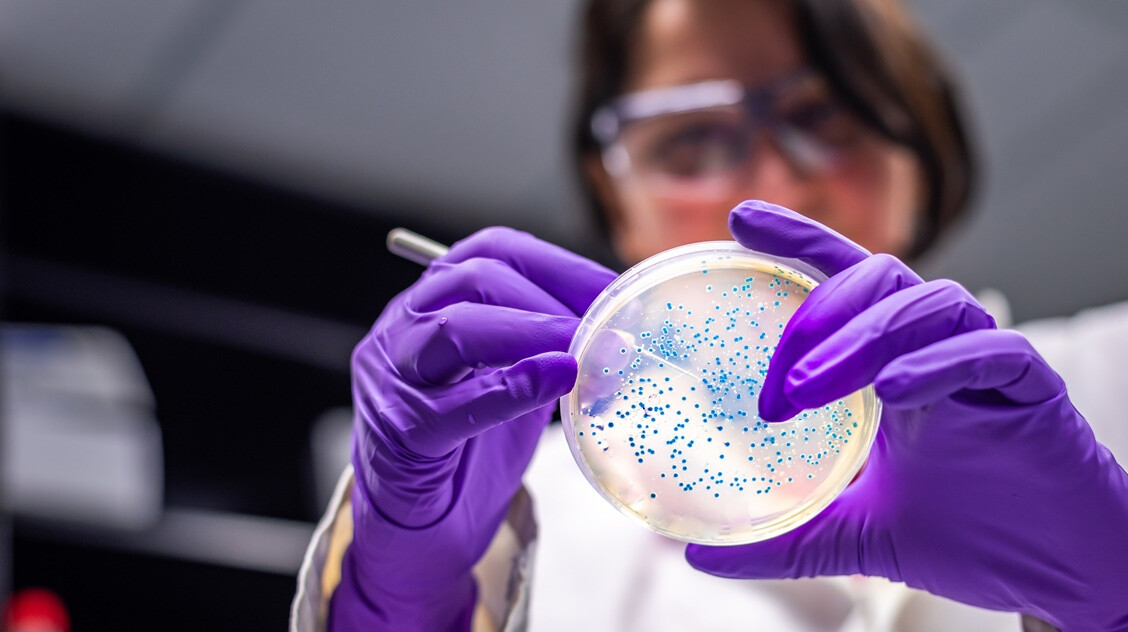
Így váltak legyőzhetetlenné a szuperbaktériumok

Az úgynevezett szuperbaktériumok mostanra ellenállóvá váltak az antibiotikumokkal szemben, vagyis a hagyományos kezelésekkel már nem lehet őket megállítani. Évente több mint egymillió haláleset köthető az antibiotikum-rezisztenciához, a közelmúltban azonban úgy tűnik, a megoldás nem a laborok mélyéről, hanem a háztartások polcairól érkezhet – írta meg a Well and Fit.
Egy nemrégiben publikált kutatás szerint a nátrium-hidrogén-karbonát, vagyis a szódabikarbóna meglepően hatékony lehet bizonyos szuperbaktériumok ellen. Az ugyanis képes megváltoztatni a baktériumok környezetének pH-értékét, ami gátolja a szaporodásukat és növeli az antibiotikumok hatékonyságát. Kísérletek során például az E. coli és a Staphylococcus aureus bizonyos törzseinél is jelentős gátló hatást figyeltek meg. Az egészségügyben való alkalmazása természetesen még kísérleti stádiumban van, és nem helyettesíti az orvosi kezelést, de az eredmények bíztatók.